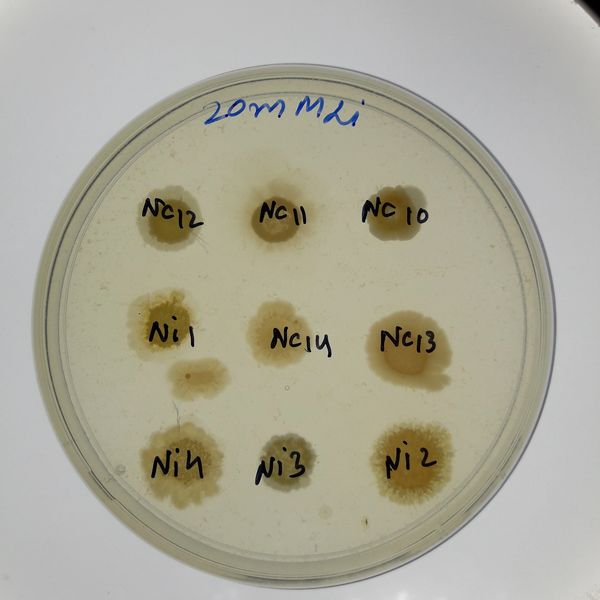

Signed in as:
filler@godaddy.com
Signed in as:
filler@godaddy.com
I started managing a virtual stock portfolio in Jan 2023 during my second quarter of a Masters of Finance at the University of California, Riverside. The aim was to learn more about the market and companies by getting real-life experience. It allowed me to make assumptions and test them as well as create strategies and perform analysis like DCF and stock comparisons and understand market movements in a more hands-on manner.
I used Perplexity AI Labs to generate a comprehensive report of the portfolio – View Full Report Here

My coding projects related to financial data analysis and modelling are listed below and linked to GitHub.

I write about my experiences and my thoughts regarding the way we live. You can read my writings here –